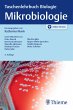
Taschenlehrbuch Biologie: Mikrobiologie... - Bild 1

Taschenlehrbuch Biologie: Mikrobiologie (eBook, PDF)
Versandkostenfrei!
Sofort per Download lieferbar
Statt: 45,00 €**
44,99 €
inkl. MwSt.
** Unverbindliche Preisempfehlung des Herstellers
Alle Infos zum eBook verschenkenWeitere Ausgaben:

PAYBACK Punkte
0 °P sammeln!
Im Bachelor-Studium der Biologie erlernst du in kurzer Zeit das Grundwissen aller biologischen Fachdisziplinen. Die Taschenlehrbuch-Reihe zur Biologie unterstützt dich dabei und vermittelt dir ein fundiertes Verständnis für biologische Zusammenhänge und Prinzipien. Bacteria, Archaea, Viren und Pilze - die vielfältigen Wege mikrobieller Energiegewinnung und Biosynthesen werden verständlich dargestellt, ebenso die molekularen und genetischen Prozesse, die den Mikroorganismen ihre enorme Anpassungsfähigkeit verleihen, ihre Bedeutung für globale Stoffkreisläufe und ihr Einsatz in der mikr...
Im Bachelor-Studium der Biologie erlernst du in kurzer Zeit das Grundwissen aller biologischen Fachdisziplinen. Die Taschenlehrbuch-Reihe zur Biologie unterstützt dich dabei und vermittelt dir ein fundiertes Verständnis für biologische Zusammenhänge und Prinzipien. Bacteria, Archaea, Viren und Pilze - die vielfältigen Wege mikrobieller Energiegewinnung und Biosynthesen werden verständlich dargestellt, ebenso die molekularen und genetischen Prozesse, die den Mikroorganismen ihre enorme Anpassungsfähigkeit verleihen, ihre Bedeutung für globale Stoffkreisläufe und ihr Einsatz in der mikrobiellen Biotechnologie. Das didaktische Konzept macht das Lesen zum Vergnügen: - Zusammenfassungen zum Kapitelbeginn führen in den Text ein und geben einen ersten Überblick. - Kurz gefasste, aber dennoch verständliche Texte mit vielen Hervorhebungen sind leicht zu erfassen. - Farbig markierte Abschnitte informieren dich über Anwendungsmöglichkeiten und über konkrete Methoden. - Zahlreiche farbige Abbildungen helfen dir, dir komplexe Sachverhalte leicht zu erschließen. - Repetitorien am Ende der Abschnitte greifen die wichtigsten neuen Begriffe nochmals auf und sind ideal zum Lernen und zum Nachschlagen! Die Taschenlehrbuch-Reihe zur Biologie – unverzichtbar für dein Studium! Jederzeit zugreifen: Der Inhalt des Buches steht dir ohne weitere Kosten digital in der Wissensplattform eRef zur Verfügung (Zugangscode im Buch). Mit der kostenlosen eRef App hast du zahlreiche Inhalte auch offline immer griffbereit.
Dieser Download kann aus rechtlichen Gründen nur mit Rechnungsadresse in A, B, BG, CY, CZ, D, DK, EW, E, FIN, F, GR, HR, H, IRL, I, LT, L, LR, M, NL, PL, P, R, S, SLO, SK ausgeliefert werden.